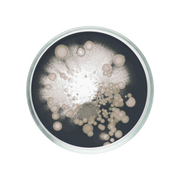
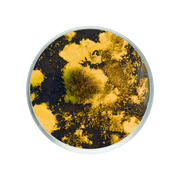
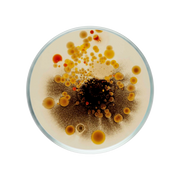
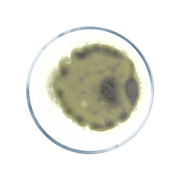

93% van onze klanten merkt verschil binnen 12 weken.
Werk doelgericht aan je gezondheid.
Hoe gezond is jouw lever?
Tot 20% korting bij langdurig gebruik. Hoe langer je blijft, hoe groter je voordeel.


10% KORTING VANAF DE START
Altijd voordeel op je maandelijkse supplementen.
FLEXIBEL ABONNEMENT
Annuleren, pauzeren of wijzigen op elk moment.
GRATIS LEVERING
Jij kiest het moment. Wij leveren automatisch en gratis aan huis.
TOT -20% LOYALITEITSKORTING
–15% na 4 maanden, –20% na 6 maanden. Loyaliteit wordt beloond bij consistent gebruik.
GRATIS JAR
Ontvang een gratis jar bij je supplementen zodat je niets vergeet en je routine eenvoudig blijft.
INNER CIRCLE TOEGANG + ADVIES
Toegang tot recepten, tips en expertadvies wanneer jij wilt.
Een overbelaste lever ligt aan de basis.
Van vermoeidheid tot gewichtstoename: veel klachten hebben dezelfde oorsprong. Insentials is gebouwd op één principe: pak de oorzaak aan, niet het symptoom.

Ontdek waar je ons kan vinden
Store Locator is loading from Storemapper...
Schrijf je in op de nieuwsbrief en krijg 10% korting op je eerste bestelling.